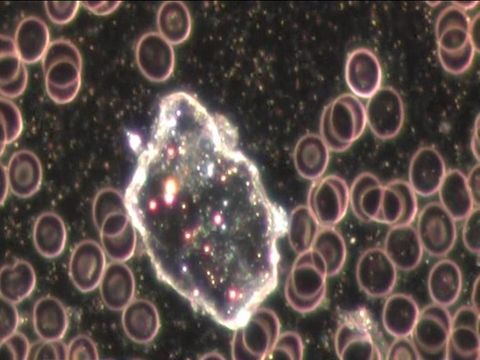

Dunkelfeld
Vitalblutbilder im Dunkelfeld
Die Dunkelfeldmikroskopie ist eine spezielle Blutuntersuchung.
Im Gegensatz zum „kleinen“ oder „großen Blutbild“ ist sie eher eine qualitative als eine quantitative Untersuchung. Dabei spielt die Ausprägung der einzelnen Blutbestandteile eine
entscheidende Rolle.
Es geht um Funktionstüchtigkeit der Zellen, nicht allein um die Anzahl. Dieses Verfahren ist somit eine erweiterte oder
ergänzende Möglichkeit der Blutdiagnostik.
Dabei spielt der Begriff der „Milieuüberprüfung“ eine zentrale Rolle, besonders bei der Therapie von Krankheiten. Mit dieser Methode hat Prof. Dr. Enderlein, der von 1872 bis 1968 lebte und seine Arbeit als Milieutherapie bezeichnete, der Medizin alternative Sichtweisen auf das Blut aufgezeigt.
Bei diesem Verfahren geht es um eine frühzeitige Sichtung von Erkrankungstendenzen. Das macht eine bessere und frühere Therapie möglich.
So wird im Dunkelfeld schon im Frühstadium einer Erkrankung über die Analyse der Zusammensetzung des Blutes sowie der krankheitstypischen Anzeichen die Möglichkeit gegeben,
frühzeitig eine Therapie zu starten.